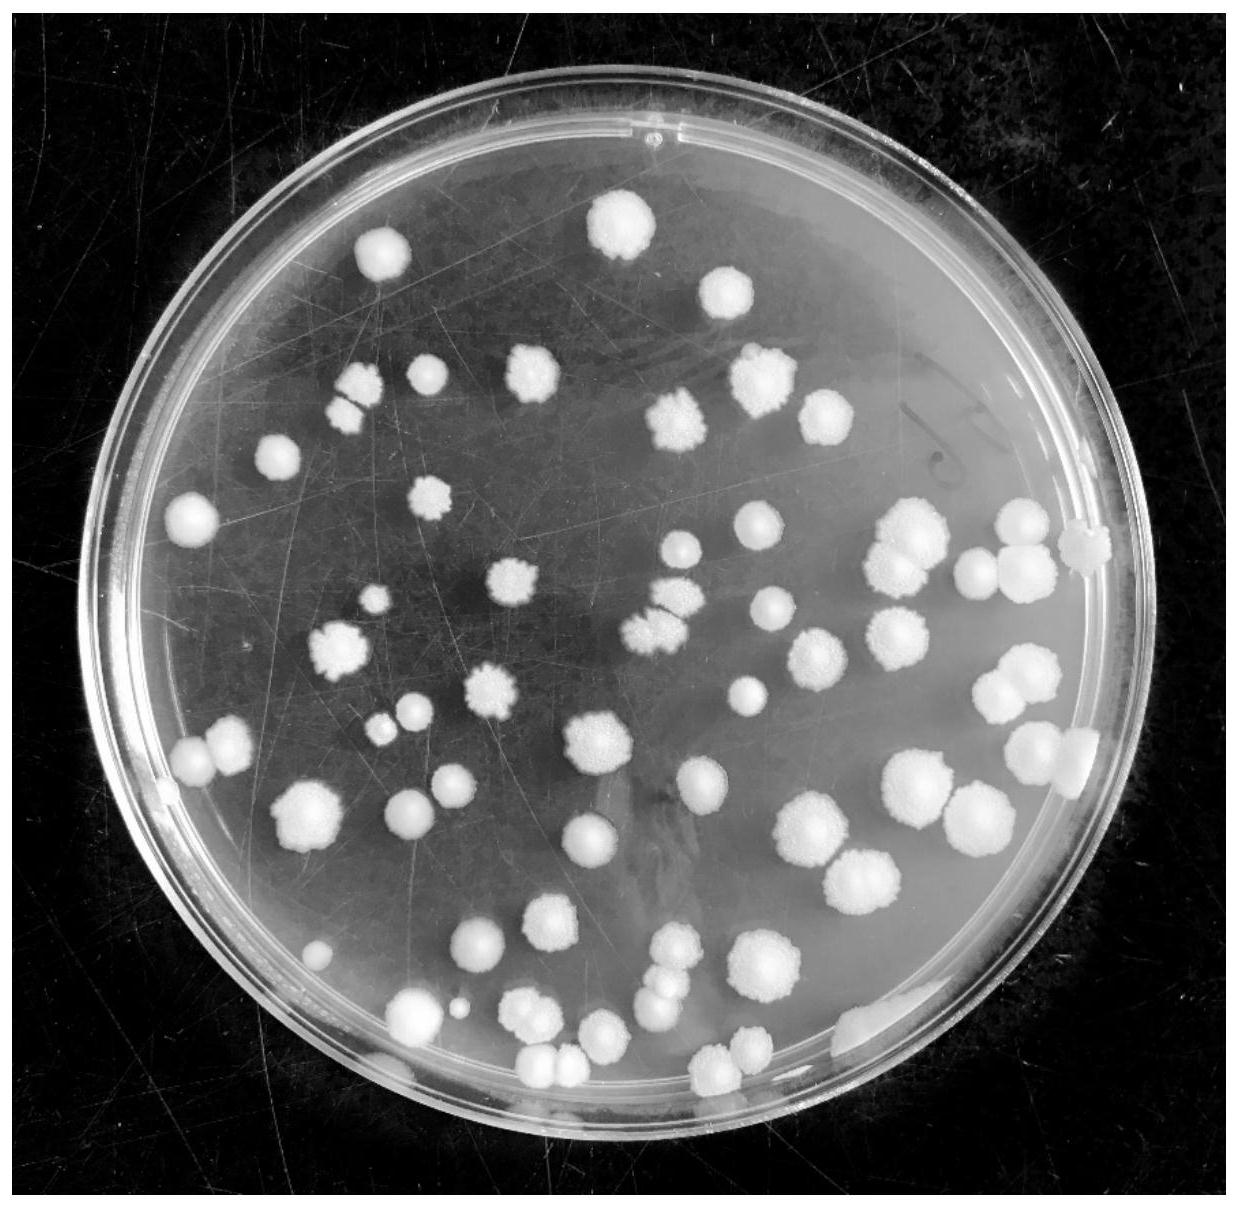
一种解淀粉芽孢杆菌菌剂制备方法及应用-爱企查
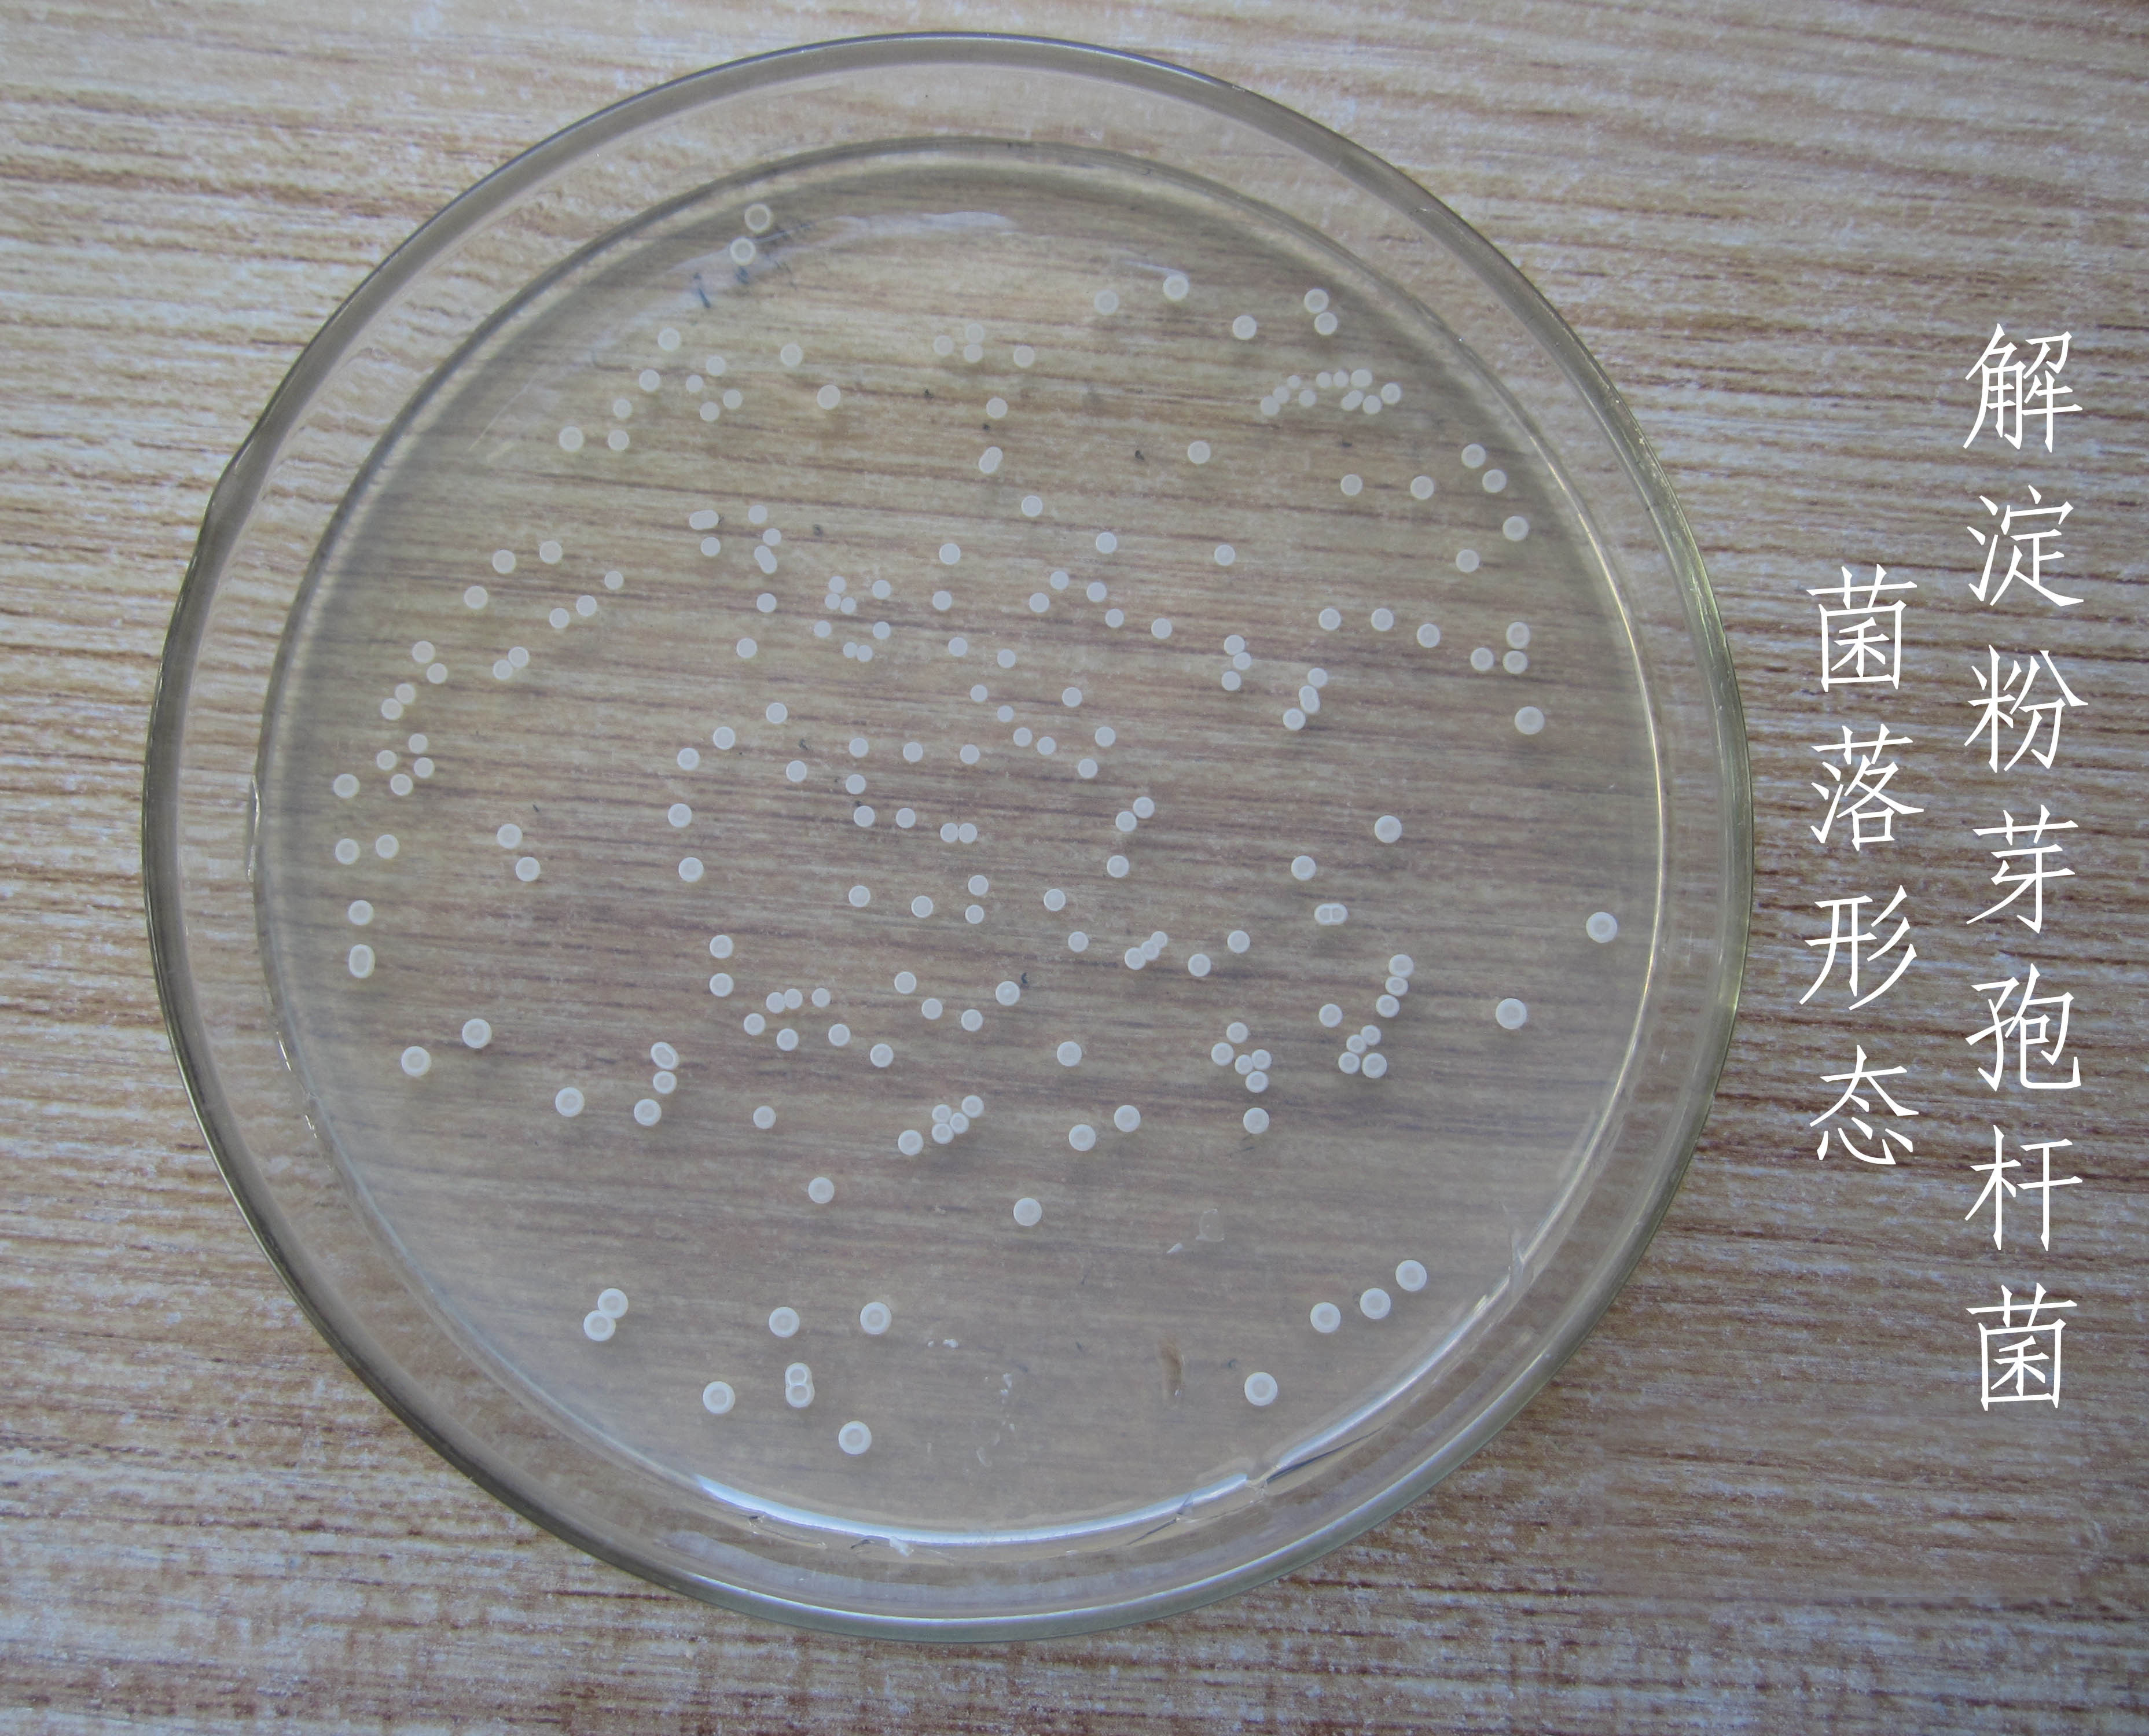
解淀粉芽孢杆菌其他生物相关

解淀粉芽孢杆菌

解淀粉芽孢杆菌高产纤维素酶菌株的筛选与鉴定
图片尺寸1575x1058
一株广谱抗菌解淀粉芽孢杆菌及其应用的制作方法
图片尺寸951x960
微生物肥料添加解淀粉芽孢杆菌厂家
图片尺寸400x400
一种解淀粉芽孢杆菌菌剂制备方法及应用-爱企查
图片尺寸1240x1208
解淀粉芽孢杆菌及其用途及其菌剂的制备方法与流程
图片尺寸1000x981
解淀粉芽孢杆菌益稼菌奥莱斯
图片尺寸580x765
一株解淀粉芽孢杆菌及其菌剂菌剂制备方法与应用与流程
图片尺寸699x524苗宝乐 解淀粉芽孢杆菌
图片尺寸1080x1080
解淀粉芽孢杆菌生产厂家供应商_天津开发区坤禾生物技术有限公司
图片尺寸3771x1355
金山微生态供应解淀粉芽孢杆菌 抗病 减少化学农药 保证食品安全 农用
图片尺寸704x528
解淀粉芽孢杆菌
图片尺寸675x900
解淀粉芽孢杆菌及其作为益生菌的应用!
图片尺寸640x640
解淀粉芽孢杆菌其他生物相关
图片尺寸3713x3000
二,解淀粉芽孢杆菌5,此外,多粘类芽孢杆菌对植物具有明显的促生长作用
图片尺寸640x705
解淀粉芽孢杆菌及其用途及其菌剂的制备方法
图片尺寸1000x981
芽孢杆菌酵母菌酵母菌在水产养殖的用途主要在幼鱼幼虾的开口饵料
图片尺寸800x602
一株解淀粉芽孢杆菌发酵产物及其制备方法与应用
图片尺寸1371x1367
cn106754529a_一株拮抗枸杞根腐病的解淀粉芽孢杆菌及其应用
图片尺寸871x874
一种具有抗菌活性的解淀粉芽孢杆菌菌株及其应用的制作方法
图片尺寸818x795
一株防治小麦赤霉病的解淀粉芽孢杆菌及其应用制造技术
图片尺寸819x835
猜你喜欢:凝结芽孢杆菌地衣芽孢杆菌贝莱斯芽孢杆菌侧孢短芽孢杆菌侧孢芽孢杆菌巨大芽孢杆菌胶冻样芽孢杆菌解淀粉芽孢杆菌图片果福来解淀粉芽孢杆菌凝结芽孢杆菌活菌片芽孢杆菌苏云金芽孢杆菌多粘类芽孢杆菌地衣芽孢杆菌活菌颗粒地衣芽孢杆菌活菌胶囊蜡样芽孢杆菌片蜡样芽孢杆菌活菌胶囊炭疽芽孢杆菌蜡样芽孢杆菌芽孢杆菌图片纳豆芽孢杆菌地衣芽孢杆菌胶囊炭疽芽孢杆菌图片苏云金芽孢杆菌图片芽孢杆菌图片显微镜炭疽芽孢杆菌革兰染色芽孢杆菌图片手绘图炭疽芽孢杆菌手绘图羧甲淀粉钠淀粉粒素衣白β-内酰胺酶q版老年人物图片机智张素颜散装东北大酱批发进口水果大全种类黑茶蓝头发我国成立100周年的画光遇雨林蜡烛位置肉末豆腐饭图片大全宝马加机油位置接机牌图片创意